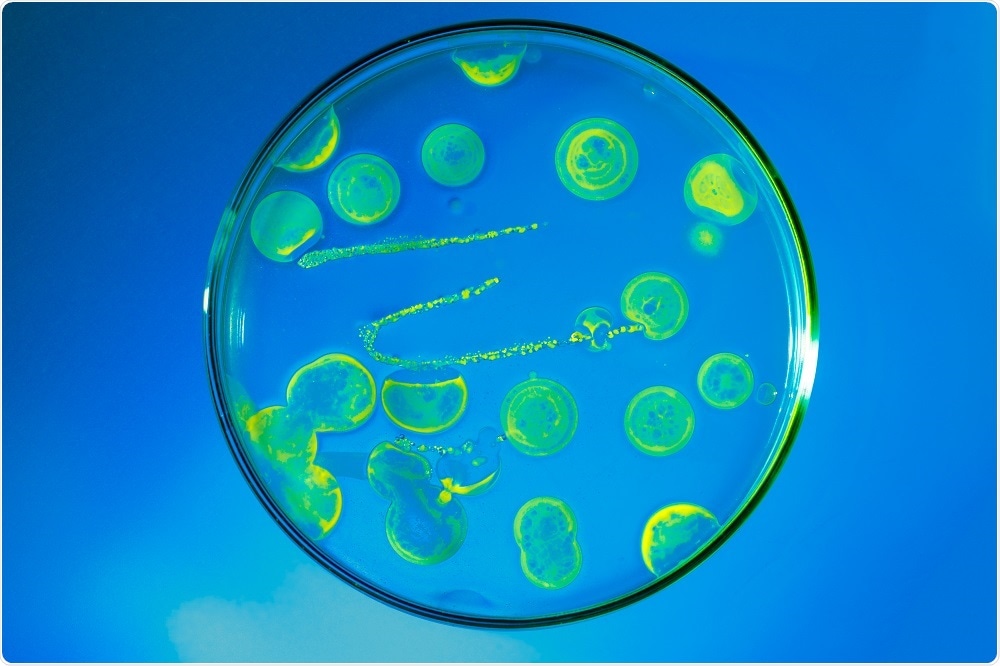

Researchers from the University of British Columbia (UBC) have developed a sustainable “biogenic” solar cell, which uses bacteria to convert light into energy and has generated the strongest current ever reported for such devices.
Image Credit: science photo / Shutterstock
Image Credit: science photo / Shutterstock
Importantly, the solar cell works just as efficiently in dim light as it does in bright light, potentially increasing the likelihood of solar power being adopted in places such as British Columbia, where skies are often overcast.
Our solution to a uniquely B.C. problem is a significant step toward making solar energy more economical.”
Vikramaditya Yadav, Project Leader
Previous attempts to make these biogenic cells have involved extracting the dye that bacteria use during photosynthesis, which is a complicated and expensive process.
As reported in the journal Small, Yadav and colleagues decided to leave the dye in the bacteria.
Working with E. coli, the scientists genetically engineered bacteria to synthesise large amounts of a dye called lycopene, a substance that is particularly efficient at converting light into energy.
After coating the E.coli with a semi-conductive mineral, they applied it to a glass surface. With this glass serving as the anode at one end of the cell, the researchers managed to produce a current density of 0.686 milliamps per cm2. That current density compares with the 0.362 per cm2 density so far achieved using other devices.
We recorded the highest current density for a biogenic solar cell. These hybrid materials that we are developing can be manufactured economically and sustainably, and, with sufficient optimization, could perform at comparable efficiencies as conventional solar cells."
Vikramaditya Yadav, Project Leader
Although the economic benefit is a little difficult to approximate, Yadav thinks the cost of producing the dye is reduced to around 10% of what it otherwise would be.
Ultimately, says Yadav, the holy grail would be to develop a process where the bacteria are not killed, so that the dye can be produced indefinitely.
He adds that other areas where the biogenic solar cells could be of value include deep-sea exploration, mining and other activities involving dimly lit environments.
Source:
https://eurekalert.org/pub_releases/2018-07/uobc-bsc062918.php